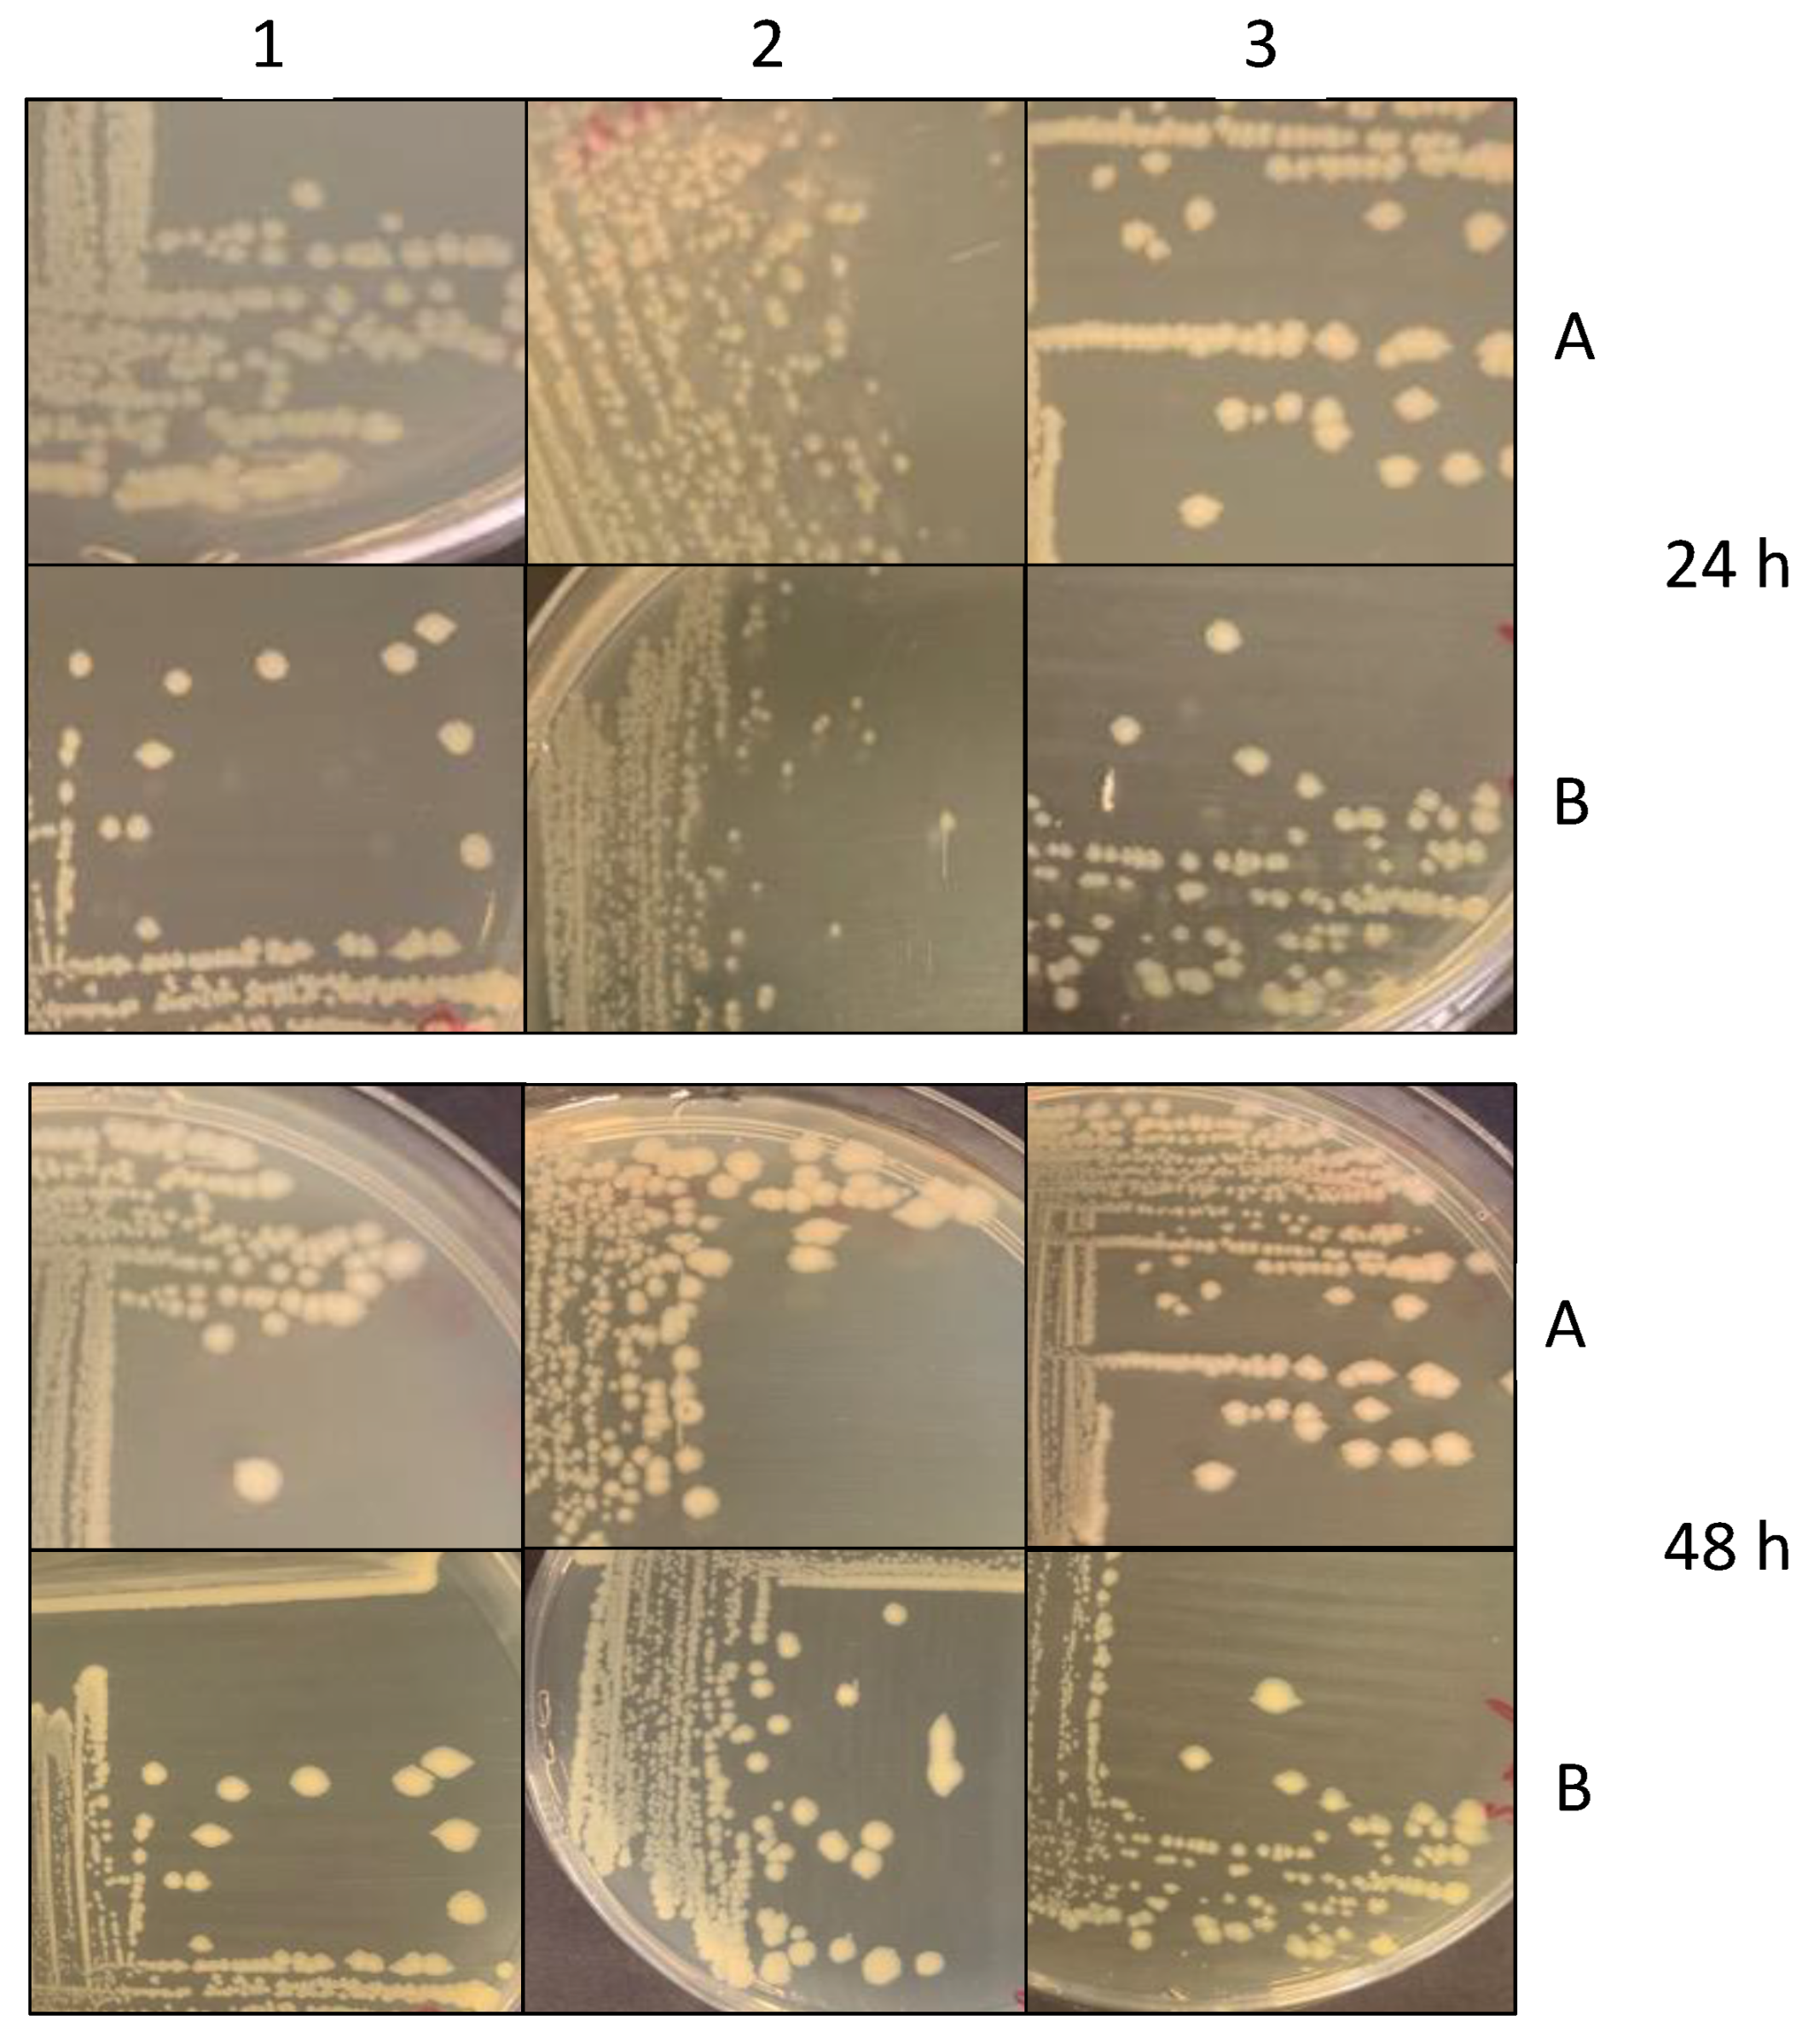
Ijms 24 00883 g006 Ijms 24 00883 g006
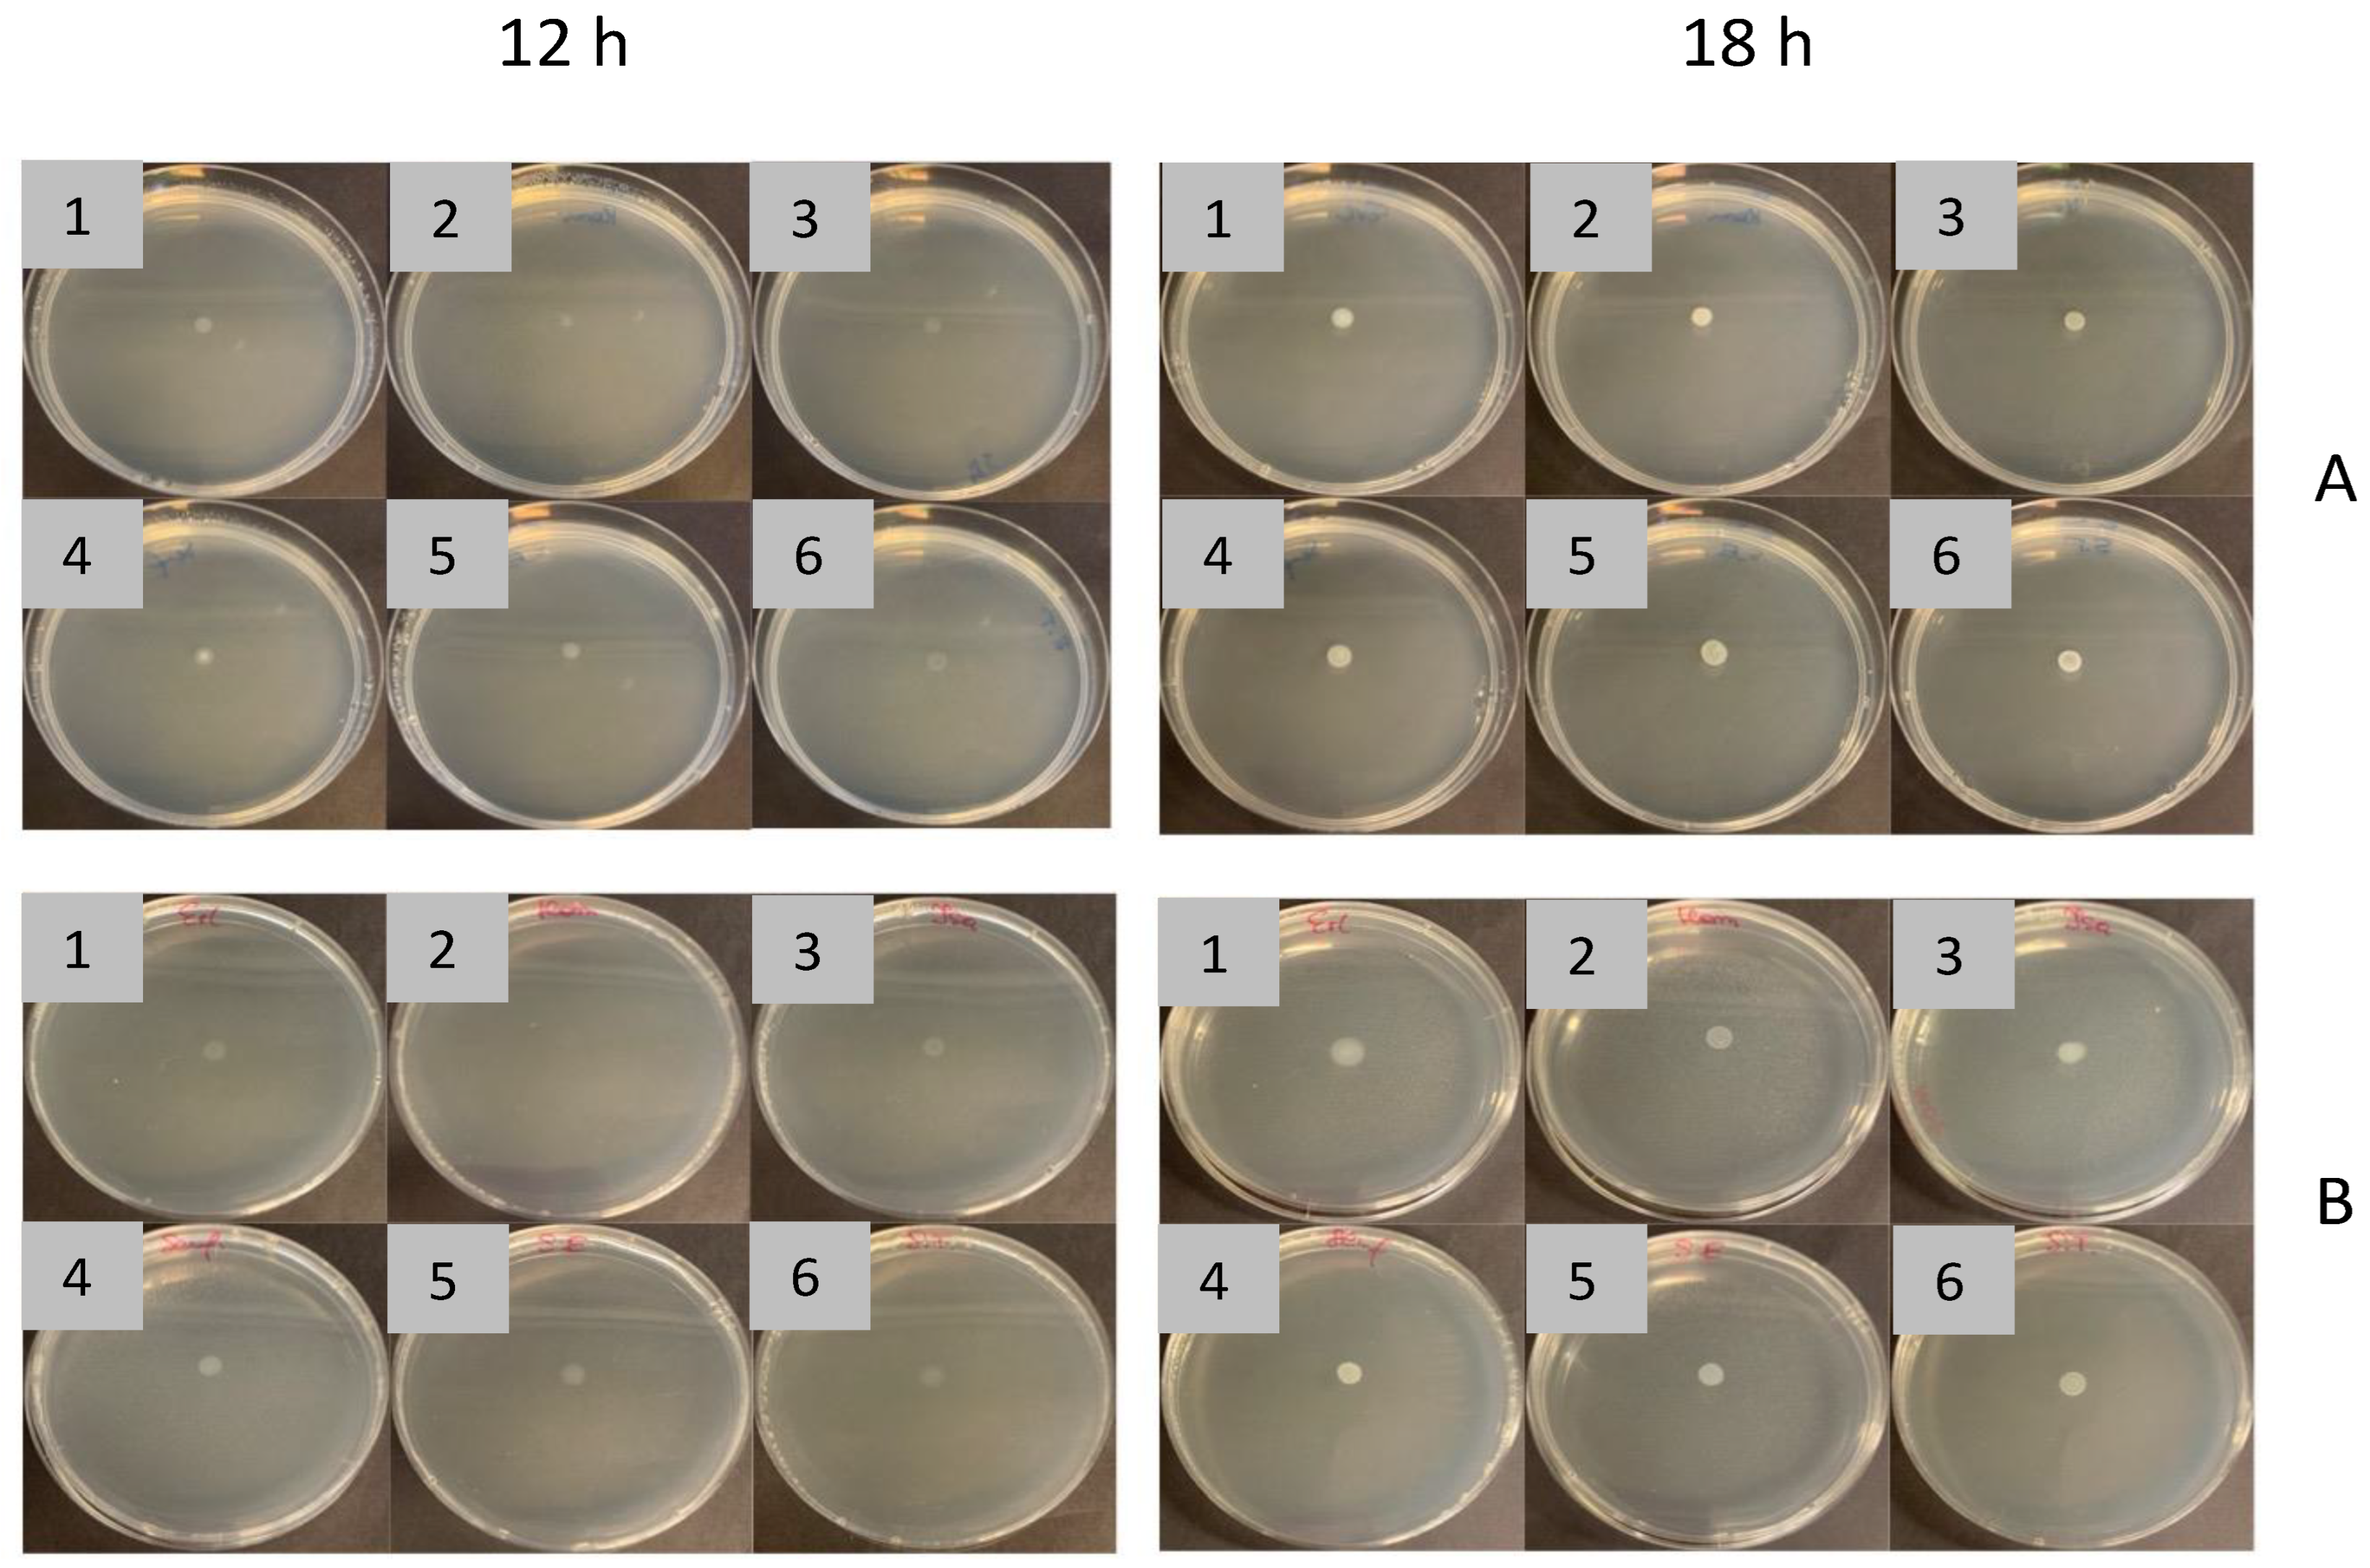
Ijms 24 00883 g007 Ijms 24 00883 g007

The Prolonged Treatment of Salmonella enterica Strains with Human Serum Effects in Phenotype Related to Virulence
Abstract
1. Introduction
2. Results
2.1. Confirmation of Salmonella Enterica with Slide Agglutination Test
2.2. Serum Susceptibility Assay
2.3. Passages of Bacteria in SPPP (Human Serum from Platelet-Poor Plasma)
2.4. Binding of C1q and C3c Complement Components to Salmonella enterica Cells
2.5. SDS-PAGE of Salmonella enterica Membrane Proteins (MPs)
2.6. Dot Blot C1q and C3c-Binding
2.7. Antibiotics and Biocides Susceptibility Profiling
2.8. Detection of Virulence Genes (VGs)
2.9. Biofilm Formation by Salmonella enterica
2.10. Cell-Surface Hydrophobicity of Salmonella enterica
2.11. Colonial Morphology of Salmonella Strains Treated and Not Treated with SPPP
2.12. Motility of Salmonella enterica Passaged and Not Passaged in 50% of SPPP
3. Discussion
4. Materials and Methods
4.1. Bacterial Strains
4.2. Sera
4.3. Antibiotics and Disinfectants
4.4. Salmonella Serum Bactericidal Assay
4.5. Prolonged Exposition (Passages) of Bacteria in SPPP (Human Serum from Platelet-Poor Plasma)
4.6. Slide Agglutination Assay
4.7. Enzyme-Linked Immunosorbent Assay (ELISA)
4.8. Membrane Proteins (MPs) Isolation and Preparation
4.9. Polyacrylamide Gel Electrophoresis (SDS-PAGE) of MPs
4.10. Molecular Analyses of MPs Patterns
4.11. Dot Blot Protein-Binding Assay
4.12. Antimicrobial Susceptibility Testing
4.13. Detection of Selected Virulence Genes (VGs)
4.14. Biofilm Formation
4.15. Cell-Surface Hydrophobicity
4.16. Colonial Morphology of Salmonella Strains
4.17. Motility Assay
4.18. Statistical Analysis
5. Conclusions
Author Contributions
Funding
Informed Consent Statement
Data Availability Statement
Acknowledgments
Conflicts of Interest
References
- Sánchez-Vargasa, F.M.; Abu-El-Haija, M.A.; Gómez-Duarte, O.G. Salmonella Infections: An Update on Epidemiology, Management, and Prevention. Travel Med. Infect. Dis. 2011, 9, 263–277. [Google Scholar] [CrossRef]
- Cummings, K.J.; Warnick, L.D.; Elton, M.; Rodriguez-Rivera, L.D.; Siler, J.D.; Wright, E.M.; Gröhn, Y.T.; Wiedmann, M. Salmonella enterica Serotype Cerro Among Dairy Cattle in New York: An Emerging Pathogen? Foodborne Pathog. Dis. 2010, 7, 659–665. [Google Scholar] [CrossRef]
- The European Union Summary Report on Trends and Sources of Zoonoses, Zoonotic Agents and Food-Borne Outbreaks in 2009. EFSA J. 2011, 9, 2090.
- Berghaus, R.D.; Thayer, S.G.; Law, B.F.; Mild, R.M.; Hofacre, C.L.; Singer, R.S. Enumeration of Salmonella and Campylobacter spp. In Environmental Farm Samples and Processing Plant Carcass Rinses from Commercial Broiler Chicken Flocks. Appl. Environ. Microbiol. 2013, 79, 4106–4114. [Google Scholar] [CrossRef] [PubMed]
- Deb, S.R.; Baral, P.; Maksud, M.; Kabira, A.; Hossain, M.; Hossain, A. A Case Report of a Male Person of 24 Years with Suspected Salmonella Induced Coronary Arteritis. J. Dhaka Med. Coll. 2014, 23, 143–146. [Google Scholar] [CrossRef]
- Gilchrist, J.J.; Rautanen, A.; Fairfax, B.P.; Mills, T.C.; Naranbhai, V.; Trochet, H.; Pirinen, M.; Muthumbi, E.; Mwarumba, S.; Njuguna, P.; et al. Risk of Nontyphoidal Salmonella Bacteraemia in African Children Is Modified by STAT4. Nat. Commun. 2018, 9, 1014. [Google Scholar] [CrossRef] [PubMed]
- Bennett, J.E.; Dolin, R.; Blaser, M.J. Mandell, Douglas, and Bennett’s Principles and Practice of Infectious Diseases; Churchill Livingstone: London, UK, 2019. [Google Scholar]
- Pedersen, T.B.; Olsen, J.E.; Bisgaard, M. Persistence of Salmonella Senftenberg in Poultry Production Environments and Investigation of Its Resistance to Desiccation. Avian Pathol. 2008, 37, 421–427. [Google Scholar] [CrossRef]
- Gamian, A.; Jones, C.; Lipiński, T.; Korzeniowska-Kowal, A.; Ravenscroft, N. Structure of The Sialic Acid-Containing O-specific Polysaccharide from Salmonella enterica Serovar Toucra O48 Lipopolysaccharide. Eur. J. Biochem. 2000, 267, 3160–3167. [Google Scholar] [CrossRef]
- Bugla-Płoskońska, G.; Rybka, J.; Futoma-Kołoch, B.; Cisowska, A.; Gamian, A.; Doroszkiewicz, W. Sialic Acid-Containing Lipopolysaccharides of Salmonella O48 Strains-Potential Role in Camouflage and Susceptibility to the Bactericidal Effect of Normal Human Serum. Microb. Ecol. 2010, 59, 601–613. [Google Scholar] [CrossRef]
- Ram, S.; Sharma, A.K.; Simpson, S.D.; Gulati, S.; Mcquillen, D.P.; Pangburn, M.K.; Rice, P.A. A Novel Sialic Acid Binding Site on Factor H Mediates Serum Resistance of Sialylated Neisseria gonorrhoeae. J. Exp. Med. 1998, 187, 743–752. [Google Scholar] [CrossRef]
- Huang, C.; Liu, Q.; Luo, Y.; Li, P.; Liu, Q.; Kong, Q. Regulated Delayed Synthesis of Lipopolysaccharide and Enterobacterial Common Antigen of Salmonella Typhimurium Enhances Immunogenicity and Cross-Protective Efficacy against Heterologous Salmonella Challenge. Vaccine 2016, 34, 4285–4292. [Google Scholar] [CrossRef][Green Version]
- Bravo, D.; Silva, C.; Carter, J.A.; Hoare, A.; Álvarez, S.A.; Blondel, C.J.; Zaldívar, M.; Valvano, M.A.; Contreras, I. Growth-Phase Regulation of Lipopolysaccharide O-Antigen Chain Length Influences Serum Resistance in Serovars of Salmonella. J. Med. Microbiol. 2008, 57, 938–946. [Google Scholar] [CrossRef] [PubMed]
- Heesterbeek, D.A.; Bardoel, B.W.; Parsons, E.S.; Bennett, I.; Ruyken, M.; Doorduijn, D.J.; Gorham, R.D.; Berends, E.T.; Pyne, A.L.; Hoogenboom, B.W.; et al. Bacterial Killing by Complement Requires Membrane Attack Complex Formation via Surface-bound C5 Convertases. EMBO J. 2019, 38, e99852. [Google Scholar] [CrossRef]
- Bugla-Płoskońska, G.; Korzeniowska-Kowal, A.; Guz-Regner, K. Reptiles as a Source of Salmonella O48-Clinically Important Bacteria for Children: The Relationship Between Resistance to Normal Cord Serum and Outer Membrane Protein Patterns. Microb. Ecol. 2011, 61, 41–51. [Google Scholar] [CrossRef]
- Pawlak, A.; Rybka, J.; Dudek, B.; Krzyżewska, E.; Rybka, W.; Kędziora, A.; Klausa, E.; Bugla-Płoskońska, G. Salmonella O48 Serum Resistance Is Connected with the Elongation of the Lipopolysaccharide O-Antigen Containing Sialic Acid. Int. J. Mol. Sci. 2017, 18, 2022. [Google Scholar] [CrossRef]
- Dudek, B.; Krzyżewska, E.; Kapczyńska, K.; Rybka, J.; Pawlak, A.; Korzekwa, K.; Klausa, E.; Bugla-Płoskońska, G. Proteomic Analysis of Outer Membrane Proteins from Salmonella Enteritidis Strains with Different Sensitivity to Human Serum. PLoS ONE 2016, 11, e0164069. [Google Scholar] [CrossRef]
- Futoma-Kołoch, B.; Dudek, B.; Kapczyńska, K.; Krzyżewska, E.; Wańczyk, M.; Korzekwa, K.; Rybka, J.; Klausa, E.; Bugla-Płoskońska, G. Relationship of Triamine-Biocide Tolerance of Salmonella enterica Serovar Senftenberg to Antimicrobial Susceptibility, Serum Resistance and Outer Membrane Proteins. Int. J. Mol. Sci. 2017, 18, 1459. [Google Scholar] [CrossRef]
- Nilsson, U.R.; Funke, L.; Nilsson, B.; Ekdahl, K.N. Two Conformational Forms of Target-Bound IC3b That Distinctively Bind Complement Receptors 1 and 2 and Two Specific Monoclonal Antibodies. Ups. J. Med. Sci. 2011, 116, 26–33. [Google Scholar] [CrossRef]
- Ricklin, D.; Reis, E.S.; Mastellos, D.C.; Gros, P.; Lambris, J.D. Complement Component C3—The “Swiss Army Knife” of Innate Immunity and Host Defense. Immunol. Rev. 2016, 274, 33–58. [Google Scholar] [CrossRef]
- Holmskov-Nielsen, U.; Jensenius, J.C.; Erb, K. Measurement of C3 Conversion by ELISA Estimation of Neo-Determinants on the C3d Moiety. J. Immunol. Methods 1986, 94, 1–6. [Google Scholar] [CrossRef]
- Futoma-Kołoch, B.; Godlewska, U.; Guz-Regner, K.; Dorotkiewicz-Jach, A.; Klausa, E.; Rybka, J.; Bugla-Płoskońska, G. Presumable Role of Outer Membrane Proteins of Salmonella Containing Sialylated Lipopolysaccharides Serovar Ngozi, Sv. Isaszeg and Subspecies Arizonae in Determining Susceptibility to Human Serum. Gut Pathog. 2015, 7, 18. [Google Scholar] [CrossRef]
- Laursen, N.S.; Pedersen, D.V.; Gytz, H.; Zarantonello, A.; Bernth Jensen, J.M.; Hansen, A.G.; Thiel, S.; Andersen, G.R. Functional and Structural Characterization of a Potent C1q Inhibitor Targeting the Classical Pathway of the Complement System. Front. Immunol. 2020, 11, 1504. [Google Scholar] [CrossRef]
- Alberti, S.; Alvarez, D.; Merino, S.; Casado, M.T.; Vivanco, F.; Tomas, J.M.; Benedi, V.J. Analysis of Complement C3 Deposition and Degradation on Klebsiella pneumoniae. Infect. Immun. 1996, 64, 4726–4732. [Google Scholar] [CrossRef]
- Roumenina, L.T.; Popov, K.T.; Bureeva, S.V.; Kojouharova, M.; Gadjeva, M.; Rabheru, S.; Thakrar, R.; Kaplun, A.; Kishore, U. Interaction of the Globular Domain of Human C1q with Salmonella Typhimurium Lipopolysaccharide. Biochim. Biophys. Acta 2008, 1784, 1271–1276. [Google Scholar] [CrossRef]
- Clas, F.; Golecki, J.R.; Loos, M. Electron microscopic study showing antibody-independent binding of C1q, a subcomponent of the first component of complement, to serum-sensitive salmonellae. Infect. Immun. 1984, 45, 795–797. [Google Scholar] [CrossRef]
- Cuypers, W.L.; Jacobs, J.; Wong, V.; Klemm, E.J.; Deborggraeve, S.; van Puyvelde, S. Fluoroquinolone Resistance in Salmonella: Insights by Whole Genome Sequencing. Microb. Genom. 2018, 4, e000195. [Google Scholar] [CrossRef]
- Parry, C.M. Typhoid Fever. Curr. Infect. Dis. Rep. 2004, 6, 27–33. [Google Scholar] [CrossRef] [PubMed]
- Obłąk, E.; Futoma-Kołoch, B.; Wieczyńska, A. Biological Activity of Quaternary Ammonium Salts and Resistance of Microorganisms to These Compounds. World J. Microbiol. Biotechnol. 2021, 37, 22. [Google Scholar] [CrossRef] [PubMed]
- Futoma-Kołoch, B.; Książczyk, M.; Korzekwa, K.; Migdał, I.; Pawlak, A.; Jankowska, M.; Kȩdziora, A.; Dorotkiewicz-Jach, A.; Bugla-Płoskońska, G. Selection and Electrophoretic Characterization of Salmonella enterica Subsp. Enterica Biocide Variants Resistant to Antibiotics. Pol. J. Vet. Sci. 2015, 18, 725–732. [Google Scholar] [CrossRef] [PubMed]
- Futoma-Kołoch, B.; Bugla-Płoskońska, G.; Dudek, B.; Dorotkiewicz-Jach, A.; Drulis-Kawa, Z.; Gamian, A. Outer Membrane Proteins of Salmonella as Potential Markers of Resistance to Serum, Antibiotics and Biocides. Curr. Med. Chem. 2018, 26, 1960–1978. [Google Scholar] [CrossRef]
- Čepl, J.; Blahůšková, A.; Neubauer, Z.; Markoš, A. Variations and Heredity in Bacterial Colonies. Commun. Integr. Biol. 2016, 9, e1261228. [Google Scholar] [CrossRef] [PubMed]
- Sousa, A.M.; Machado, I.; Nicolau, A.; Pereira, M.O. Improvements on Colony Morphology Identification Towards Bacterial Profiling. J. Microbiol. Methods. 2013, 95, 327–335. [Google Scholar] [CrossRef] [PubMed]
- Fazly Bazzaz, B.S.; Darvishi Fork, S.; Ahmadi, R.; Khameneh, B. Deep Insights into Urinary Tract Infections and Effective Natural Remedies. Afr. J. Urol. 2021, 27, 6. [Google Scholar] [CrossRef]
- Drumm, B.; Neumann, A.W.; Policova, Z.; Sherman, P.M. Bacterial Cell Surface Hydrophobicity Properties in the Mediation of in Vitro Adhesion by the Rabbit Enteric Pathogen Escherichia coli Strain RDEC-1. J. Clin. Investig. 1989, 84, 1588–1594. [Google Scholar] [CrossRef]
- Karygianni, L.; Ren, Z.; Koo, H.; Thurnheer, T. Biofilm Matrixome: Extracellular Components in Structured Microbial Communities. Trends Microbiol. 2020, 28, 668–681. [Google Scholar] [CrossRef]
- Beshiru, A.; Igbinosa, I.H.; Igbinosa, E.O. Biofilm Formation and Potential Virulence Factors of Salmonella Strains Isolated from Ready-to-Eat Shrimps. PLoS ONE 2018, 13, e0204345. [Google Scholar] [CrossRef]
- Sharma, D.; Misba, L.; Khan, A.U. Antibiotics versus Biofilm: An Emerging Battleground in Microbial Communities. Antimicrob. Resist. Infect. Control 2019, 8, 76. [Google Scholar] [CrossRef]
- Futoma-Kołoch, B.; Puchała, A.; Bugla-Płoskońska, G. Interaction of Complement System Components with Bacterial Outer Membrane Proteins and Presentation of Techniques Useful in Studying These Interactions. Anti-Infect. Agents 2016, 14, 100–105. [Google Scholar] [CrossRef]
- Reeks, B.Y.; Champlin, F.R.; Paulsen, D.B.; Scruggs, D.W.; Lawrence, M.L. Effects of Sub-Minimum Inhibitory Concentration Antibiotic Levels and Temperature on Growth Kinetics and Outer Membrane Protein Expression in Mannheimia haemolytica and Haemophilus somnus. Can. J. Vet. Res. 2005, 69, 1–10. [Google Scholar]
- DE Orange, N.; Saint, N.; Gurillon, J.; de Mot, R.; Molle, G. Growth Temperature Dependence of Channel Size of the Major Outer-Membrane Protein (OprF) in Psychrotrophic Pseudomonas fluorescens Strains. Microbiology 1997, 143, 1029–1035. [Google Scholar] [CrossRef][Green Version]
- Lo, M.; Cordwell, S.J.; Bulach, D.M.; Adler, B. Comparative Transcriptional and Translational Analysis of Leptospiral Outer Membrane Protein Expression in Response to Temperature. PLoS Negl. Trop. Dis. 2009, 3, e560. [Google Scholar] [CrossRef] [PubMed]
- Lamas, A.; Fernandez-No, I.C.; Miranda, J.M.; Vázquez, B.; Cepeda, A.; Franco, C.M. Biofilm Formation and Morphotypes of Salmonella enterica Subsp. Arizonae Differs from Those of Other Salmonella enterica Subspecies in Isolates from Poultry Houses. J. Food Prot. 2016, 79, 1127–1134. [Google Scholar] [CrossRef] [PubMed]
- Laupland, K.B.; Schønheyder, H.C.; Kennedy, K.J.; Lyytikäinen, O.; Valiquette, L.; Galbraith, J.; Collignon, P. Salmonella enterica Bacteraemia: A Multi-National Population-Based Cohort Study. BMC Infect. Dis. 2010, 10, 95. [Google Scholar] [CrossRef] [PubMed]
- Graham, S.M.; Walsh, A.L.; Molyneux, E.M.; Phiri, A.J.; Molyneux, M.E. Clinical Presentation of Non-Typhoidal Salmonella Bacteraemia in Malawian Children. Trans. R. Soc. Trop. Med. Hyg. 2000, 94, 310–314. [Google Scholar] [CrossRef] [PubMed]
- Mandomando, I.; Macete, E.; Sigaúque, B.; Morais, L.; Quintó, L.; Sacarlal, J.; Espasa, M.; Vallès, X.; Bassat, Q.; Aide, P.; et al. Invasive Non-Typhoidal Salmonella in Mozambican Children. Trop. Med. Int. Health 2009, 14, 1467–1474. [Google Scholar] [CrossRef]
- MacLennan, C.A.; Gondwe, E.N.; Msefula, C.L.; Kingsley, R.A.; Thomson, N.R.; White, S.A.; Goodall, M.; Pickard, D.J.; Graham, S.M.; Dougan, G.; et al. The Neglected Role of Antibody in Protection against Bacteremia Caused by Nontyphoidal Strains of Salmonella in African Children. J. Clin. Investig. 2008, 118, 1553–1562. [Google Scholar] [CrossRef]
- Meri, S.; Pangburn, M.K. Discrimination between Activators and Nonactivators of the Alternative Pathway of Complement: Regulation via a Sialic Acid/Polyanion Binding Site on Factor H. Proc. Natl. Acad. Sci. USA 1990, 87, 3982–3986. [Google Scholar] [CrossRef]
- Goh, Y.S.; MacLennan, C.A. Invasive African Nontyphoidal Salmonella Requires High Levels of Complement for Cell-Free Antibody-Dependent Killing. J. Immunol. Methods 2013, 387, 121–129. [Google Scholar] [CrossRef]
- Somerville, G.A.; Beres, S.B.; Fitzgerald, J.R.; DeLeo, F.R.; Cole, R.L.; Hoff, J.S.; Musser, J.M. In Vitro Serial Passage of Staphylococcus aureus: Changes in Physiology, Virulence Factor Production, and Agr Nucleotide Sequence. J. Bacteriol. 2002, 184, 1430–1437. [Google Scholar] [CrossRef]
- Mankoski, R.; Hoepf, T.; Krakowka, S.; Eaton, K.A. mRNA Transcription Level Correlates with Helicobacter Pylori Colonisation Efficiency in Gnotobiotic Piglets. J. Med. Microbiol. 1999, 48, 395–399. [Google Scholar] [CrossRef]
- Alberti, S.; Marques, G.; Camprubi, S.; Merino, S.; Tomas, J.M.; Vivanco, F.; Benedi, V.J. Clq Binding and Activation of the Complement Classical Pathway by Klebsiella pneumoniae Outer Membrane Proteins. Infect. Immun. 1993, 61, 852–860. [Google Scholar] [CrossRef] [PubMed]
- Andrade, F.F.; Silva, D.; Rodrigues, A.; Pina-Vaz, C. Colistin Update on Its Mechanism of Action and Resistance, Present and Future Challenges. Microorganisms 2020, 8, 1716. [Google Scholar] [CrossRef] [PubMed]
- El-Sayed Ahmed, M.A.E.G.; Zhong, L.L.; Shen, C.; Yang, Y.; Doi, Y.; Tian, G.B. Colistin and Its Role in the Era of Antibiotic Resistance: An Extended Review (2000–2019). Emerg. Microbes. Infect. 2020, 9, 868–885. [Google Scholar] [CrossRef] [PubMed]
- Fortini, D.; Owczarek, S.; Dionisi, A.M.; Lucarelli, C.; Arena, S.; Carattoli, A.; Villa, L.; García-Fernández, A.; Helfer, F.; Aschbacher, R.; et al. Colistin Resistance Mechanisms in Human Salmonella enterica Strains Isolated by the National Surveillance Enter-Net Italia (2016–2018). Antibiotics 2022, 11, 102. [Google Scholar] [CrossRef] [PubMed]
- Lyu, Z.; Yang, A.; Villanueva, P.; Singh, A.; Ling, J. Heterogeneous Flagellar Expression in Single Salmonella Cells Promotes Diversity in Antibiotic Tolerance. mBio 2021, 12, e02374-21. [Google Scholar] [CrossRef] [PubMed]
- Arrieta-Gisasola, A.; Atxaerandio-Landa, A.; Garrido, V.; Grilló, M.J.; Martínez-Ballesteros, I.; Laorden, L.; Garaizar, J.; Bikandi, J. Genotyping Study of Salmonella 4,[5],12: I:-Monophasic Variant of Serovar Typhimurium and Characterization of the Second-Phase Flagellar Deletion by Whole Genome Sequencing. Microorganisms 2020, 8, 2049. [Google Scholar] [CrossRef]
- Duangurai, T.; Reamtong, O.; Rungruengkitkun, A.; Srinon, V.; Boonyuen, U.; Limmathurotsakul, D.; Chantratita, N.; Pumirat, P. In Vitro Passage Alters Virulence, Immune Activation and Proteomic Profiles of Burkholderia pseudomallei. Sci. Rep. 2020, 10, 8320. [Google Scholar] [CrossRef]
- Carrascosa, C.; Raheem, D.; Ramos, F.; Saraiva, A.; Raposo, A. Microbial Biofilms in the Food Industry—A Comprehensive Review. Int. J. Environ. Res. Pub. Health 2021, 18, 2014. [Google Scholar] [CrossRef]
- Rosenberg, M.; Judes, H.; Weiss, E. Cell Surface Hydrophobicity of Dental Plaque Microorganisms in Situ. Infect. Immun. 1983, 42, 831–834. [Google Scholar] [CrossRef]
- Rozgonyi, F.; Szitha, K.R.; Ljungh, Å.; Baloda, S.B.; Hjertén, S.; Wadström, T. Improvement of the Salt Aggregation Test to Study Bacterial Cell-Surface Hydrophobicity. FEMS Microbiol. Lett. 1985, 30, 131–138. [Google Scholar] [CrossRef][Green Version]
- Haiko, J.; Westerlund-Wikström, B. The Role of the Bacterial Flagellum in Adhesion and Virulence. Biology 2013, 2, 1242–1267. [Google Scholar] [CrossRef] [PubMed]
- de Oliveira, D.C.V.; Fernandes Júnior, A.; Kaneno, R.; Silva, M.G.; Araújo Júnior, J.P.; Silva, N.C.C.; Rall, V.L.M. Ability of Salmonella Spp. to Produce Biofilm Is Dependent on Temperature and Surface Material. Foodborne Pathog. Dis. 2014, 11, 478–483. [Google Scholar] [CrossRef] [PubMed]
- Jahan, F.; Chinni, S.V.; Samuggam, S.; Reddy, L.V.; Solayappan, M.; Su Yin, L. The Complex Mechanism of the Salmonella Typhi Biofilm Formation That Facilitates Pathogenicity: A Review. Int. J. Mol. Sci. 2022, 23, 6462. [Google Scholar] [CrossRef]
- Laemmli, U.K. Cleavage of Structural Proteins during the Assembly of the Head of Bacteriophage T4. Nature 1970, 227, 680–685. [Google Scholar] [CrossRef]
- National Committee for Clinical Laboratory Standards. Performance Standards for Antimicrobial Disc Susceptibility Tests, 6th ed.; National Committee for Clinical Laboratory Standards: Malvern, PA, USA, 1997. [Google Scholar]
- The European Committee on Antimicrobial Susceptibility Testing. Routine and Extended Internal Quality Control for MIC Determination and Disk Diffusion as Recommended by EUCAST. Version 11.0. 2021. Available online: http://www.eucast.org (accessed on 9 December 2021).
- Schug, A.R.; Bartel, A.; Scholtzek, A.D.; Meurer, M.; Brombach, J.; Hensel, V.; Fanning, S.; Schwarz, S.; Feßler, A.T. Biocide Susceptibility Testing of Bacteria: Development of a Broth Microdilution Method. Vet. Microbiol. 2020, 248, 108791. [Google Scholar] [CrossRef]
- McQuiston, J.R.; Parrenas, R.; Ortiz-Rivera, M.; Gheesling, L.; Brenner, F.; Fields, P.I. Sequencing and Comparative Analysis of Flagellin Genes FliC, FljB, and FlpA from Salmonella. J. Clin. Microbiol. 2004, 42, 1923–1932. [Google Scholar] [CrossRef][Green Version]
- Skyberg, J.A.; Logue, C.M.; Nolan, L.K. Virulence Genotyping of Salmonella spp. With Multiplex PCR. Avian Dis. 2006, 50, 77–81. [Google Scholar] [CrossRef]
- Lee, K.; Iwata, T.; Shimizu, M.; Taniguchi, T.; Nakadai, A.; Hirota, Y.; Hayashidani, H. A Novel Multiplex PCR Assay for Salmonella Subspecies Identification. J. Appl. Microbiol. 2009, 107, 805–811. [Google Scholar] [CrossRef]
- Samykannu, G.; Vijayababu, P.; Antonyraj, C.B.; Narayanan, S. Structural Investigation of APRs to Improve the Solubility of Outer Membrane Protease (PgtE) from Salmonella enterica Serotype Typhi- A Multi-Constraint Approach. Biochem. Biophys. Rep. 2020, 21, 100693. [Google Scholar] [CrossRef]
- Chen, S.; Feng, Z.; Sun, H.; Zhang, R.; Qin, T.; Peng, D. Biofilm-Formation-Related Genes CsgD and BcsA Promote the Vertical Transmission of Salmonella Enteritidis in Chicken. Front. Vet. Sci. 2021, 7, 625049. [Google Scholar] [CrossRef]
- O’Toole, G.A.; Kolter, R. Initiation of Biofilm Formation in Pseudomonas fluorescens WCS365 Proceeds via Multiple, Convergent Signalling Pathways: A Genetic Analysis. Mol. Microbiol. 1998, 28, 449–461. [Google Scholar] [CrossRef] [PubMed]
- Siegfried, L.; Kmeiovat, M.; Puzova, H.; Molokacovas, M.; Filkag, J. Virulence-Associated Factors in Escherichia Coli Strains Isolated from Children with Urinary Tract Infections, J. Med. Microbiol. 1994, 41, 127–132. [Google Scholar] [CrossRef] [PubMed]
- Ray, S.; da Costa, R.; Thakur, S.; Nandi, D. Salmonella Typhimurium Encoded Cold Shock Protein E Is Essential for Motility and Biofilm Formation. Microbiology 2020, 166, 460–473. [Google Scholar] [CrossRef]

| Salmonella enterica Subsp. enterica Serovars | ||||||||||||||||||
|---|---|---|---|---|---|---|---|---|---|---|---|---|---|---|---|---|---|---|
| Sera | Typhimurium ATCC 14028 | Enteritidis ATCC 13076 | Senftenberg | Isaszeg * | Erlangen * | Hammonia * | ||||||||||||
| CFU/mL−1 | Survival Rate of Cells at T3 [%] | CFU/mL1 | Survival Rate of Cells at T3 [%] | CFU/mL−1 | Survival Rate of Cells at T3 [%] | CFU/mL−1 | Survival Rate of Cells at T3 [%] | CFU/mL−1 | Survival Rate of Cells at T3 [%] | CFU/mL−1 | Survival Rate of Cells at T3 [%] | |||||||
| T0 | T3 | T0 | T3 | T0 | T3 | T0 | T3 | T0 | T3 | T0 | T3 | |||||||
| 50% SPPP | 1.5 × 106 | 8.8 × 102 | 0.06 | 1.6 × 106 | 5.6 × 102 | 0.04 | 1.5 × 106 | 5.8 × 102 | 0.04 | 1.5 × 106 | 3.4 × 105 | 22.7 | 1.5 × 106 | 1.2 × 105 | 8.0 | 1.5 × 106 | 3.5 × 105 | 23.3 |
| 50% HI SPPP | 1.7 × 106 | 2.0 × 106 | 117.6 | 1.8 × 106 | 2.2 × 106 | 122.2 | 1.6 × 106 | 1.6 × 106 | 100.0 | 1.3 × 106 | 1.5 × 106 | 115.4 | 1.2 × 106 | 1.3 × 106 | 108.3 | 1.3 × 106 | 1.4 × 106 | 107.7 |
| Strain | Antibiotic | Biocide | |||||||
|---|---|---|---|---|---|---|---|---|---|
| AMP | AMC | COL | CTX | CIP | TMP-SMX | Virusolve+® | Desprej® | BAC | |
| S. Isaszeg (SS) | 2 (S) | 2 (S) | 2 (S) | 0.25 (S) | 0.25 (R) | 32 (R) | 0.03 | 12.5 | 0.006 |
| S. Isaszeg P8 (SR) | 2 (S) | 0.75 (S) | 2 (S) | 0.25 (S) | 0.5 (R) | 32 (R) | 0.06 | 25.0 | 0.006 |
| S. Erlangen (SS) | 2 (S) | 2 (S) | 4 (R) | 0.25 (S) | 0.25 (R) | 20 (R) | 0.03 | 6.25 | 0.003 |
| S. Erlangen P8 (SR) | 2 (S) | 0.5 (S) | 4 (R) | 0.25 (S) | 0.25 (R) | 20 (R) | 0.06 | 12.5 | 0.006 |
| S. Hammonia (SS) | 2 (S) | 2 (S) | 2 (S) | 0.25 (S) | 0.25 (R) | 32 (R) | 0.03 | 12.5 | 0.003 |
| S. Hammonia P8 (SR) | 1 (S) | 2 (S) | 4 (R) | 1.5 (S) | 0.25 (R) | 24 (R) | 0.03 | 6.25 | 0.003 |
| S. Typhimurium ATCC 14028 (SS) | 1 (S) | 2 (S) | 4 (R) | 0.25 (S) | 0.25 (R) | 20 (R) | 0.03 | 12.5 | 0.006 |
| S. Typhimurium ATCC 14028 P8 (SS) | 1 (S) | 2 (S) | 4 (R) | 0.25 (S) | 0.25 (R) | 20 (R) | 0.03 | 12.5 | 0.006 |
| S. Enteritidis ATCC 13076 (SS) | 1 (S) | 2 (S) | 4 (R) | 0.25 (S) | 0.25 (R) | 64 (R) | 0.015 | 3.13 | 0.003 |
| S. Enteritidis ATCC 13076 P8 (SR) | 1 (S) | 2 (S) | 4 (R) | 0.25 (S) | 0.25 (R) | 64 (R) | 0.015 | 3.13 | 0.003 |
| S. Senftenberg (SS) | 1 (S) | 0.5 (S) | 6 (R) | 1.5 (S) | 0.75 (R) | 24 (R) | 0.06 | 25 | 0.012 |
| S. Senftenberg P8 (SS) | 1 (S) | 2 (S) | 4 (R) | 0.5 (S) | 0.25 (R) | 24 (R) | 0.03 | 12.5 | 0.003 |
| Strain | Gene | |||||||
|---|---|---|---|---|---|---|---|---|
| invA | pagC | tolC | pgtE | fljB | fliC | OmpR | csgD | |
| S. Isaszeg (SS) | ||||||||
| S. Erlangen (SS) | ||||||||
| S. Hammonia (SS) | ||||||||
| S. Typhimurium ATCC 14028 (SS) | ||||||||
| S. Enteritidis ATCC 13076 (SS) | ||||||||
| S. Senftenberg (SS) | ||||||||
| S. Isaszeg P8 (SR) | ||||||||
| S. Erlangen P8 (SR) | ||||||||
| S. Hammonia P8 (SR) | ||||||||
| S. Typhimurium ATCC 14028 P8 (SS) | ||||||||
| S. Enteritidis ATCC 13076 P8 (SR) | ||||||||
| S. Senftenberg P8 (SS) | ||||||||
| Strain | Biofilm Formation | |
|---|---|---|
| 28 °C | 37 °C | |
| S. Isaszeg (SS) | strong | strong |
| S. Isaszeg P8 (SR) | strong | strong |
| S. Erlangen (SS) | strong | moderate |
| S. Erlangen P8 (SR) | strong | strong |
| S. Hammonia (SS) | strong | strong |
| S. Hammonia P8 (SR) | strong | strong |
| S. Typhimurium ATCC 14028 (SS) | strong | strong |
| S. Typhimurium ATCC 14028 P8 (SS) | strong | moderate |
| S. Enteritidis ATCC 13076 (SS) | moderate | moderate |
| S. Enteritidis ATCC 13076 P8 (SR) | strong | moderate |
| S. Senftenberg (SS) | strong | strong |
| S. Senftenberg P8 (SS) | strong | moderate |
| Salmonella Strain | Salt Aggregation Test (SAT) |
|---|---|
| S. Isaszeg (SS) | strong hydrophobicity (1.0 M) |
| S. Isaszeg P8 (SR) | very strong hydrophobicity (0.2 M) |
| S. Erlangen (SS) | very strong hydrophobicity (0.2 M) |
| S. Erlangen P8 (SR) | very strong hydrophobicity (0.2 M) |
| S. Hammonia (SS) | very strong hydrophobicity (0.2 M) |
| S. Hammonia P8 (SR) | very strong hydrophobicity (0.2 M) |
| S. Typhimurium ATCC 14028 (SS) | hydrophobic (1.2 M) |
| S. Typhimurium ATCC 14028 P8 (SS) | very strong hydrophobicity (0.2 M) |
| S. Enteritidis ATCC 13076 (SS) | very strong hydrophobicity (0.2 M) |
| S. Enteritidis ATCC 13076 P8 (SR) | very strong hydrophobicity (0.2 M) |
| S. Senftenberg (SS) | very strong hydrophobicity (0.2 M) |
| S. Senftenberg P8 (SS) | very strong hydrophobicity (0.2 M) |
| Salmonella enterica Subspecies | Serovar | Somatic (O) Antigen | Flagellar (H) Antigen | Designation in This Work | Source | Human Serum Susceptibility Phenotype | NeuAc/Kdo Ratio [10] |
|---|---|---|---|---|---|---|---|
| enterica | Isaszeg | 48 | z10:e,n,x | S. Isaszeg | PCM 2550 IP 886/71 | Sensitive * [10] | 0 |
| salamae | Erlangen | 48 | g,m,t:- | S. Erlangen | PCM 2533 NBIMCC 17259 | Sensitive * [10] | 90 |
| salamae | Hammonia | 48 | e,n,x,z15:z6 | S. Hammonia | PCM 2535 NBIMCC 1503 | Sensitive * [10] | 260 |
| enterica | Typhimurium | 1,4,[5],12 | i,1,2 | S. Typhimurium | ATCC 14028 | Sensitive **, this study | NT |
| enterica | Enteritidis | 1,9,12 | g,m,- | S. Enteritidis | ATCC 13076 | Sensitive **, this study | NT |
| enterica | Senftenberg | 1,3,19 | g,[s],t,- | S. Senftenberg | Sensitive **, this study | NT | |
| enterica | Isaszeg | 48 | z10:e,n,x | S. Isaszeg P8 | PCM 2550 IP 886/71 | Resistant **, this study/Resistant *** [16] | NT |
| salamae | Erlangen | 48 | g,m,t:- | S. Erlangen P8 | PCM 2533 NBIMCC 17259 | Resistant **, this study/Resistant *** [16] | NT |
| salamae | Hammonia | 48 | e,n,x,z15:z6 | S. Hammonia P8 | PCM 2535 NBIMCC 1503 | Resistant **, this study/Resistant *** [16] | NT |
| enterica | Typhimurium | 1,4,[5],12 | i,1,2 | S. Typhimurium P8 | ATCC 14028 | Sensitive **, this study | NT |
| enterica | Enteritidis | 1,9,12 | g,m,- | S. Enteritidis P8 | ATCC 13076 | Resistant **, this study | NT |
| Gene | Primer Sequence 5′ → 3′ | Gene Function | NCBI Gene ID | Ref. |
|---|---|---|---|---|
| invA | F–ACAGTGCTCGTTTACGACCTGAAT R–AGACGACTGGTACTGATCGATAAT | III secretion system apparatus protein | 1254419 | [71] |
| pagC | F–CGCCTTTTCCGTGGGGTATGC R–GAAGCCGTTTATTTTTGTAGAGGAGATGTT | Outer membrane protein, serum resistance | 1252764 | [70] |
| tolC | F–TACCCAGGCGCAAAAAGAGGCTATC R–CCGCGTTATCCAGGTTGTTGC | Outer membrane channel, efflux system | 1254709 | [70] |
| pgtE | F–GCCCCCATATGCTTAATATTCAAA ATTATTCCGC R–CGCCATGGTTATCCTTGCAGGAAGC | Outer membrane protease, serum resistance | 1253917 | [72] |
| fljB | F–GACTCCATCCAGGCTGAAATCAC R–CGGCTTTGCTGGCATTGTAG | Phase 2 flagellin, flagellar synthesis | 1254294 | [71] |
| fliC | F–GCGCGGAATAATGAGGCATAAAGC R–GCTTTCGCTGCCTTGATTGTGT | Filamental structural protein, phase-1-I flagellin | 1253480 | [69] |
| OmpR | F–CGGATGTGCCGGATCTTCTT R–GTTACGTCGTCAGGCAAACG | Two-component system response regulator, biofilm formation | 1255025 | [73] |
| csgD | F–CATGTTTAATGAAGTCCATAGTAGTC R–TTACCGCCTGAGATTATCGTTTG | Transcriptional regulator, biofilm formation | 1252660 | [73] |
Disclaimer/Publisher’s Note: The statements, opinions and data contained in all publications are solely those of the individual author(s) and contributor(s) and not of MDPI and/or the editor(s). MDPI and/or the editor(s) disclaim responsibility for any injury to people or property resulting from any ideas, methods, instructions or products referred to in the content. |
© 2023 by the authors. Licensee MDPI, Basel, Switzerland. This article is an open access article distributed under the terms and conditions of the Creative Commons Attribution (CC BY) license (https://creativecommons.org/licenses/by/4.0/).
Share and Cite
Futoma-Kołoch, B.; Małaszczuk, M.; Korzekwa, K.; Steczkiewicz, M.; Gamian, A.; Bugla-Płoskońska, G. The Prolonged Treatment of Salmonella enterica Strains with Human Serum Effects in Phenotype Related to Virulence. Int. J. Mol. Sci. 2023, 24, 883. https://doi.org/10.3390/ijms24010883
Futoma-Kołoch B, Małaszczuk M, Korzekwa K, Steczkiewicz M, Gamian A, Bugla-Płoskońska G. The Prolonged Treatment of Salmonella enterica Strains with Human Serum Effects in Phenotype Related to Virulence. International Journal of Molecular Sciences. 2023; 24(1):883. https://doi.org/10.3390/ijms24010883
Chicago/Turabian StyleFutoma-Kołoch, Bożena, Michał Małaszczuk, Kamila Korzekwa, Małgorzata Steczkiewicz, Andrzej Gamian, and Gabriela Bugla-Płoskońska. 2023. "The Prolonged Treatment of Salmonella enterica Strains with Human Serum Effects in Phenotype Related to Virulence" International Journal of Molecular Sciences 24, no. 1: 883. https://doi.org/10.3390/ijms24010883
APA StyleFutoma-Kołoch, B., Małaszczuk, M., Korzekwa, K., Steczkiewicz, M., Gamian, A., & Bugla-Płoskońska, G. (2023). The Prolonged Treatment of Salmonella enterica Strains with Human Serum Effects in Phenotype Related to Virulence. International Journal of Molecular Sciences, 24(1), 883. https://doi.org/10.3390/ijms24010883

